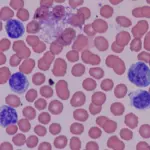
Cos'è la basofilia? Cause e sintomi

Redazione
Articoli di Redazione
Cos'è la basofilia? Cause e sintomi
13 nov 2020

Ritardo mentale e quoziente intellettivo
12 nov 2020

Come si calcolano le settimane di gravidanza
30 ott 2020

Vitamina D: i vantaggi e le sue proprietà
12 ott 2020

Che cos’è il Regulatory Affairs Specialist
08 ott 2020

Disfunzione erettile, come vincerla senza traumi
05 ott 2020



